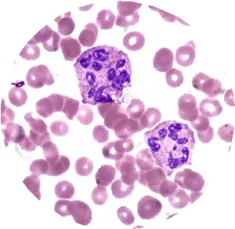
ph

EMicrobes from Envicare for the challenging Sewage
and
Effluent Treatment Plants
Bioremediation is a waste management technique that involves the use of bacteria to neutralize pollutants
What is EMicrobes OR BIOCULTURE ?
Envicare’s Effective Microorganisms (EM) are mixed cultures of beneficial naturally-occurring organisms that can be applied as inoculants to increase the microbial activity in the waste water
How our EMicrobes is superior than others?
- Available at most reasonable price.
- Bacterial Count : > Billion CFU per ML having more than 76 strains of BACTERIA.
- Lesser Quantity Required.
- Ensures faster reaction.
FEATURES:
- Nature: Our Effective Microorganisms are Facultative in nature
- Bacterial Count : Billion cfu per ml having more than 56 strains of bacteria
- Application pH: 4 to 10
- Application Temperature: 10- 55 degree C
- Self Life: 9 months
- Genus: B.licheniformis, B. thurengenis, B.polymyxa, B.sterothemophilus, Penicillium sp., Aspergillus sp., Flavobacterium, Arthrobacter, Pseudomonas, Streptomyces, Saccaromyces, Triphoderma, etc
Regular formulation, normally, do not initially have enzymes but only microbes which produce enzymes. Our EM solution action is faster as enzymes already exist in the formulation.
| Ingredient Name | CAS No | |
| Cellulase | 9012-54-8 & 9004-53-9 | |
| Fungal Lipase | 9001-62-1 | |
| Nervanase | 9000-90-2 | |
| Proteinase | 12211-28-8 & 130498-22-5 | |
How EMicrobes is financially beneficial?
- With the use of our EMicrobes you will be able to reduce the operating cost by 20-50%
- The cost of our EMicrobes is less than the cost of additives, they require less storage space, are easy to dose and have a greater shelf life.
- Once you dose our EMicrobes there is no need to dose any other additives.
- Also there are numerous problems associated with the use of additives
The most commonly used additives are :
- Urea- Nitrogen Source
- DAP (Di ammonium Phosphate)
- Phosphate Source Jaggery- Carbon
- Source
Problems associated with commonly used additives :
- Unavailability of Urea & DAP in soluble form at microbial level
- Becomes difficult for generic microbes to break down Urea and DAP.Further many other
- Formulations of urea are coated with neem which is anti-microbial in nature
- Industrial grade Urea-DAP have a high cost
- High transportation cost
- Big storage space required
- Hygroscopic in nature, hence needs specific storage conditions.
Comparison
| Biotech | Additives | |
| Availability | Easily Available | Not easily available |
| Usage | Easy to dose | Not easy |
| Dosage | less | high |
| Under Stress Conditions | Effective | Generally Fails |
| Transportation Cost | Low | high |
| Storage Space | less | More |
| Anti Microbial In nature | No | Neam Coated Urea are anti microbial in nature |
| Hygroscopic in Nature | No | Yes |

- Zero cost of any other nutrients.
- Reduction in energy consumption.
- You achieve improved results.
Classification of bacteria based on pH & temperature

Acidophiles acid :loving organisms grow at pH values lower than 5.4
Neutrophiles grow at pH values from 5.4 to 8.5

Alkalinophiles or base :loving organisms grow at pH values from 7 to 11.5

Psychrophiles are cold-loving organisms and grow best at tem- peratures from 12oC to 18oC. Their range of temperatures for growth is from - 10oC to 30oC.

Mesophiles consist of the largest group of organisms and grow best at temperatures from 25oC to 40oC. Their range of temperatures for growth is 20oC to 50oC

Thermophiles are heat-loving organisms and grow best at temperatures from 50oC to 65oC. Their range of temperatures for growth is from 35 to 75°C

- Lag: Time for bacteria to “adjust” to their new environment Enzymes produced for the degradation of substrate. No increase in bacterial mass
- Log: Substrate is adsorbed and absorbed. Substrate is degraded Cellular synthesis occurs.Rapid increase in bacterial mass
- Stationary: Carrying capacity of the environment is reached Growth rate equals death rate Bacterial mass remains relatively constant
- Death: Substrate decreases. Accumulation of wastes occurs. Death rate greater than growth rate. Bacterial mass decreases
Common contaminants & stress in
Microbial - Abiotic & Biotic stress
• Significant abiotic factors include alkalinity, ionized ammonia (NH4+), dissolved oxygen, hydraulic retention time (HRT), nutrients, pH, quantity and types of substrates, return activated sludge (RAS) rate, temperature, toxic wastes, and turbulence.
• Significant biotic factors include denitrifying bacteria, filamentous organisms, floc-forming bacteria, mean cell residence time (MCRT) or sludge age, mixed liquor volatile suspended solids (MLVSS) concentration, nitrifying bacteria, and relative abundance and dominant groups of protozoa.
Common contaminants in wastewater
- suspended solids
- pollutants
- organic load
- refractory organics
- pathogens
- dissolved inorganics
- heavy metals
Why EMicrobes are important?
Other than numerous Financial Benefits EMicrobes ensures a scientific approach to achieving controlled, predictable and programmed bioremediation. It involves the addition of specific aerobic bacteria which have been pre-adapted under the conditions, where it is to act while augmenting the existing system
EMicrobes allow you to control the nature of the biomass. It ensures that only the team of effective microbes is present in sufficient quantity in wastewater to achieve proper degradation of organic load and even harsh pollutants.
EMicrobes not only consist of enzyme producing bacteria but initial enzymes for better and rapid results.
The microorganisms in EMicrobes and their enzyme system are more efficient in degrading a larger variety of substrates than other biomass.
The EMicrobes microorganisms have unique abilities to survive and remain active even under harsh environmental and operational conditions that are not tolerated by other biomass
Even under various abiotic and biotic stress, due to a unique formulation of EMicrobes, they are able to remain active and continue to degrade organic compounds.
In addition to active enzymes, it contains macro, micro and secondary nutrients, amino acids, vitamins, proteins, carbohydrates and minerals.
Once you join hands with us we ensure that not only you are provided with the best product and also we provide needed support and guidance to achieve the desired results.
Impact of EMicrobes on performance

- Commissioning: Faster and quicker commissioning of the biological units.
- Efficiency: Higher efficiency due to robust biomass
- Stability: Rock solid stability during upsets as compared to other biomass.
- Recovery: Faster recovery after a major upset
Impact of enzymes

Enzymes are a type of complex protein that are found in all living things. Hundreds of enzymes are present in most cells, and enzymes are constantly manufactured. Enzymes are biological processes catalysts. Enzymes may speed up processes by up to 1 million times the pace of uncatalyzed reactions and allow biological reactions to take place at temperatures that live cells can tolerate
Enzymes serve as a surface or active location for biological events to take place. The active site is a binding site, which means it creates a weak connection with the molecules on which the enzyme functions. Enzymes, on the other hand, are particular in terms of the substrates or substances that they may destroy or manufacture
When a substrate comes in contact with an appropriate site of an enzyme, an enzyme - substrate complex is formed. Once the complex is formed, chemical bonds in the substrate are weakened, and the substrate is degraded by catabolism to simpler molecules as shown in the above pictorial as 1,2,3
EMicrobes - The solution !!

Further added advantages of EMicrobes
EMicrobes helps to maintain proper MLSS and effective microorganisms in the system to ensure proper degradation of organic load. Able to tackle harsh and complex pollutants and improves water quality The degradation capacity of EMicrobes is very high and ensure rapid biodegradation of conventional organics as well as harsh and complex pollutants like oil, phenol, etc It also reduces total and focal coliform count


Coagulants and Flocculants are added for the purpose of removal and clarification of Total Suspended Solids. Industries use a large number of chemicals which ultimately results in the generation of Sludge. EMicrobes are capable to degrade the suspended solids in the pre chemical tank resulting in a nominal quantity of solids which are to be treated by the use of the nominal quantity of chemicals. Due to the lesser consumption of chemicals, there is a reduced generation of sludge. This also reduces the chemical cost
Our EM being facultative in nature does not become totally ineffective and continues to degrade the organic load.


It is also observed that intrinsic bacteria act on the organic matter at a slow rate and their oxygen uptake rate is also high, requiring a high level of Dissolved Oxygen for survival while EMicrobes require just 0.5 mg/l of DO for survival there by reducing the aeration cost
Nutrients are only added to provide food to the intrinsic bacteria which are consumed by both effective and non-effective bacteria thereby not ensuring the proper count of effective and usable bacteria.


EMicrobes is available in ready to use nature and need no further additions like jaggery etc
Other varieties :
- Aerobic Digestion for Effluent Treatment Plant
- Effective Microbes for Septic Tank Treatment
- Effective Microbes for development of MLVSS
- Effective Microbes for Composting
- Effective Microbes for Anaerobic Digestor
- Oil & Grease Degradation
- Hydrocarbon Degradation especially in Automobile Sector
- Effective Microbes for Soil Fertility and Crop Production
- Nutrients for Biomass
- Effective Microbes for treatment of Drain
Above data is compulsory to understand your requirement and to proceed further.
- Effluent Treatment Plants ( ETP )
- Sewage Treatment Plants ( STP )
- Bag Filtration Systems
- Filter Presses
- Demineralised ( DM ) Water Treatment Plant
- Automatic Water Softener
- Oil Skimmers
- Reverse Osmosis ( RO ) Water Treatment Plant
- Water Purifiers
- Water Treatment Plants ( WTP )
- Rain Water Harvesting ( RWH )
- STP, ETP, WTP, WWTP AMC ( Annual Maintenance Contract ) Services
- Pollution Control Board ( PCB ) Compliances
- R&D Laboratory
- E-Microbes For Problematic STP and ETP New















